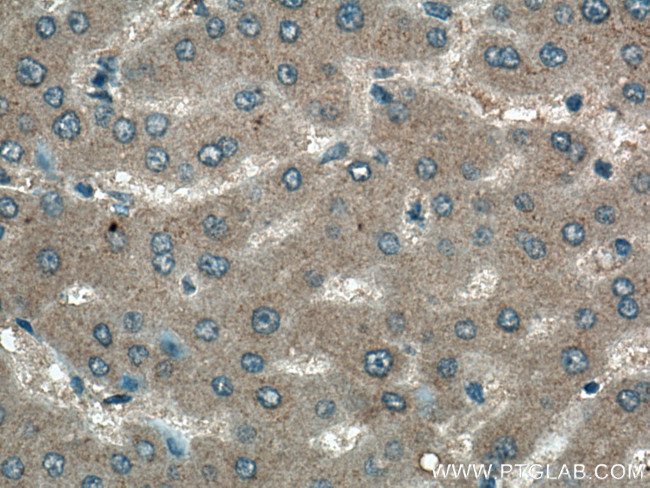
EPO Antibody in Immunohistochemistry (Paraffin) (IHC (P))

Search
Proteintech
EPO Monoclonal Antibody (1A11F3)
{{$productOrderCtrl.translations['antibody.pdp.commerceCard.promotion.promotions']}}
{{$productOrderCtrl.translations['antibody.pdp.commerceCard.promotion.viewpromo']}}
{{$productOrderCtrl.translations['antibody.pdp.commerceCard.promotion.promocode']}}: {{promo.promoCode}} {{promo.promoTitle}} {{promo.promoDescription}}. {{$productOrderCtrl.translations['antibody.pdp.commerceCard.promotion.learnmore']}}
产品信息
66975-1-IG
种属反应
宿主/亚型
分类
类型
克隆号
抗原
偶联物
形式
浓度
规格
纯化类型
保存液
内含物
保存条件
运输条件
产品详细信息
Aliquoting is unnecessary for -20°C storage.
靶标信息
Erythropoietin (EPO) protein is a growth factor essential for the survival, proliferation, and differentiation of erythroid precursors. EPO is not responsible for early commitment to the lineage, and instead induces the final maturation of partially differentiated erythroid cells and the production of red cell-specific proteins, such as hemoglobin. The EPO receptor (EPOR) is present in higher levels on precursor cells, and expression diminishes with cell maturation.Hepatocytes are the main source of EPO in the fetus, followed by interstitial cells of the kidney after birth and through adulthood. EPO expression is upregulated during hypoxia, and low levels of transcription have also been detected in lung and brain tissue under these conditions. Recent data suggest that EPO may also play a role in the protection of neuronal tissue from damage and initiation of repair.
仅用于科研。不用于诊断过程。未经明确授权不得转售。
生物信息学
蛋白别名: epoetin; Erythropoietin; MGC138142; unnamed protein product
基因别名: DBAL; ECYT5; EP; EPO; MVCD2
UniProt ID: (Human) P01588, (Mouse) P07321
Entrez Gene ID: (Human) 2056, (Mouse) 13856